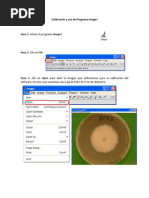

0% encontró este documento útil (2 votos)
526 vistas8 páginasTécnicas de Coloración en Biología
Este documento describe los pasos para preparar muestras secas y frescas para su observación microscópica. Explica que una muestra seca requiere extender, fijar y teñir la muestra en el portaobjetos, mientras que una muestra fresca solo requiere colocar la muestra directamente en el portaobjetos con un cubreobjetos. Además, destaca la importancia de las técnicas de tinción para mejorar el contraste y permitir distinguir características de los microorganismos.
Cargado por
Juliette RosalesDerechos de autor
© © All Rights Reserved
Nos tomamos en serio los derechos de los contenidos. Si sospechas que se trata de tu contenido, reclámalo aquí.
Formatos disponibles
Descarga como DOCX, PDF, TXT o lee en línea desde Scribd
0% encontró este documento útil (2 votos)
526 vistas8 páginasTécnicas de Coloración en Biología
Este documento describe los pasos para preparar muestras secas y frescas para su observación microscópica. Explica que una muestra seca requiere extender, fijar y teñir la muestra en el portaobjetos, mientras que una muestra fresca solo requiere colocar la muestra directamente en el portaobjetos con un cubreobjetos. Además, destaca la importancia de las técnicas de tinción para mejorar el contraste y permitir distinguir características de los microorganismos.
Cargado por
Juliette RosalesDerechos de autor
© © All Rights Reserved
Nos tomamos en serio los derechos de los contenidos. Si sospechas que se trata de tu contenido, reclámalo aquí.
Formatos disponibles
Descarga como DOCX, PDF, TXT o lee en línea desde Scribd